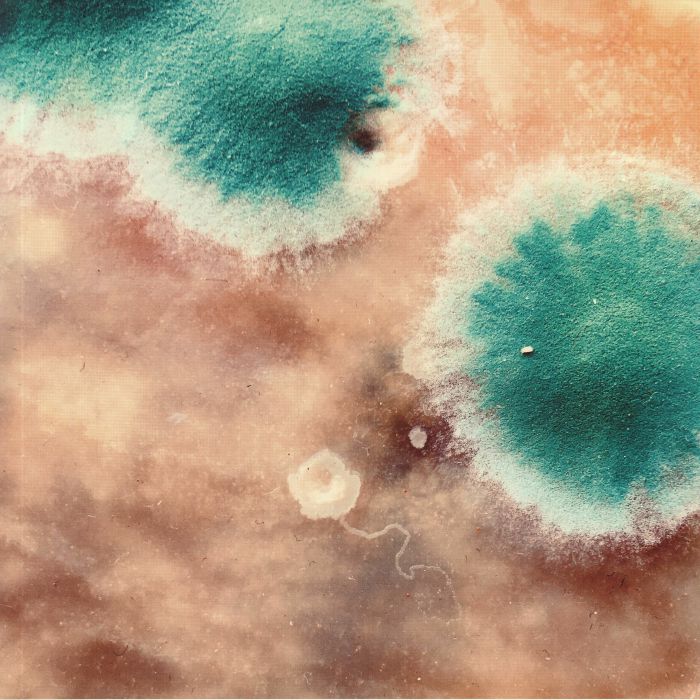
SHACKLETON / ZIMPEL - Primal Forms

1
/
of
1
Cosmo Rhythmatic
SHACKLETON / ZIMPEL - Primal Forms
SHACKLETON / ZIMPEL - Primal Forms
Regular price
£23.40 GBP
Regular price
Sale price
£23.40 GBP
Unit price
/
per
Taxes included.
Shipping calculated at checkout.
Couldn't load pickup availability
Format: LP
Cat: CR 012
Released: 5th August 2020
Genre: Experimental/Electronic
Cat: CR 012
Released: 5th August 2020
Genre: Experimental/Electronic
Share